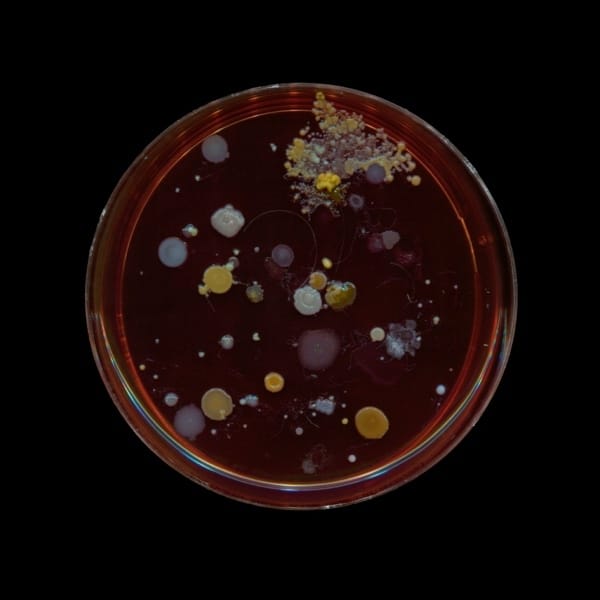

Hello,
Everyone’s talking about Michelin, but I have other worries. The apartment next to me flooded, caused by a “very large blockage of hair” in our building’s shared wastewater pipe. It made an ungodly smell waft through the foyer until someone thought to cover it up by burning some temple-level incense. The whole incident has made me wonder about the ethical implications of being so incredibly relieved that my apartment was not the victim in this whole ordeal; yesterday I heard the loud whirring of a commercial dehumidifier running inside and hurriedly unlocked my own door so I didn’t have to think about what it was like beyond their door any further.
I don’t know if it’s worth thinking about Michelin, considering the money has been paid and the judges have already been dining in our restaurants for the past year, according to an article in the Herald. I have asked at least two restaurateurs already if they’d noticed any judge-like diners, but, lo and behold, our restaurants already seem to enjoy a decent level of patronage from tourists with European accents, and I’ve been told it’s impossible to tell. The fork-dropping test is apparently a folk tale and is to be blamed on Bradley Cooper’s 2015 film Burnt, which, in addition to introducing this lie into pop culture, was also a bad movie.
Although I could feel my old crotchety food writer self start to rear up upon reading the news about Michelin, my feelings on the matter somewhat dulled down upon having what I would describe as an “excellent” meal on Monday at Tempero on Karangahape Rd. I could not begrudge a Michelin judge the opportunity to eat the heirloom tomato salad that we had, drizzled in annatto oil, or the wagyu picanha, medium rare, slathered with a layer of homemade beans. It made me think about how Michelin is clearly not for us, on the ground and so enraged about the whole thing. It’s clearly for someone else, a someone else that wants to discover some nice food after flying here for 15 hours straight. Let it just be for someone else.
Love,
Jean
P.S. If you want to hear me be more contrarian on the topic, in which I do explore whether or not it’ll actually have any impact on the hospitality industry, then I have some good news: I did record an ATE ATE ATE podcast episode that will be out soon, in which I more or less rag on Michelin and question its credibility at length. What can I say, I am mercurial.
RUMOUR MILL: Gay sauna institution Centurian, which has been in Beresford Square off Karangahape Rd for as long as any of us can remember, is rumoured to be closing down and moving to another location closer to the Cordis. It will apparently have a bar, a stage and be serving food and drinks (so you don’t have to leave).
Edibles.
OPENINGS AND CLOSINGS
UNCLE MAN has just opened another branch in the central city on Lorne St. Hoardings had been heralding their arrival for ages, so it’s quite an anticlimactic moment. Expect the same menu you know and love.
MIBO has opened another branch in Milford. It serves Flight Coffee and lots of decadent pastries, which I recommend.
If you’re a Bike Guy, there’s a coffee spot in Mt Roskill called OUTSET that looks to also be a bike shop? They sell Cheese on Toast toasties too.
The matcha bar by Namu Group, HONEYMOON AVENUE, is opening tomorrow (Friday). Expect “ceremonial-grade matcha beverages, delightful desserts – like banana pudding and mango mint shaved ice-creams, and new-aged photobooths.” New-aged photobooths is an interesting turn of phrase.

ALERT: HOT CHEF AT OPEN
NEWS AND EVENTS
GAZA COLA, made by the Palestine House in London, is being imported into Aotearoa, with all profits going to the Karama Hospital in Gaza. I’ve seen it available at Gemmayze St in St Kevin’s Arcade and Burnt Butter Diner in Avondale, with more to follow suit, I’m sure. If you want to stock it, you CAN REACH OUT HERE. Side note, there is a PLANTS FOR PALESTINE EVENT on this Sunday 16 November. If you can’t go, think about buying a FEW RAFFLE TICKETS. The prize bundles are very, very good.
Friend of the newsletter, Open Late, will be HOSTING A POP-UP featuring chef/model Dominique Harris tomorrow, Friday night. The menu includes blackened chicken and stuffed Iranian dates. Yum!
THE SOUTH NATURAL WINE FESTIVAL, featuring producers like Amoise, Halcyon Days, Silver Wing and more is on this Saturday 15 November at Pocket Bar in Grey Lynn. Featuring jazz.
McDonalds has announced it will be serving wings. Wings!
Whinge.
by Mike

THE DELTA TAVERN IN NGĀRUAWĀHIA. 4 STARS ON GOOGLE.
One must do all that one can to entice the tourists off their all-inclusive cruise ships and into our economy, and preferably, according to Mayor Brown, they should enter via Queen Street’s luxury stores. He’s concerned, however, that these boutiques are being hampered by “scruffy-looking” unhoused people whose presence nearby is assumed to drain visitors' desire for $3000 handbags. Perhaps, the mayor suggests, a solution might be for the Government to remove these Aucklanders to “the countryside”? After all, "if there’s a scruffy-looking person sitting outside a pub in Ngāruawāhia right now, it’s probably not enchanting, but it’s probably not closing off wealthy foreign tourists from spending a lot of money here.” (AN ACTUAL QUOTE). A stark reminder of where priorities lie – not in funding programmes such as EMERGENCY HOUSING GRANTS to help people off the streets and into accommodation, but rather to literally move the issue out of sight and out of mind. Brown certainly has a mandate after winning a majority of all votes cast last month, but not, it would seem, the humaneness to match.
Auctioneering.
Items from the liquidation sales of Auckland’s two-speed recovery.
By Simon

THE WAVI SCAN EEG SYSTEM. YOURS FOR POSSIBLY $55.
WAVI SCAN EEG SYSTEM
Current bid $55, Closes Wednesday
Summer nights can be long and dull, so why not buy this brain scanner and invite some people round for drinks, dinner and brain scans. Comes with headsets in three sizes so no one needs to miss out.
ABAXIS PICCOLO XPRESS CHEMISTRY ANALYZER
Current bid $15, Closes Wednesday
Hypochodria? Make it a thing of the past – not with boring and expensive psychotherapy – but by knowing for sure, by analysing your blood every single day, at home, with this preloved piece of diagnostic equipment. Performs 31 different blood tests at once with only a 12-minute wait time for the results.
PALATINO SAXOPHONE
Current bid $145, Closes Tuesday
There was once a time when the single hottest thing you could do was play a saxophone and given the circular nature of modern culture, you might as well get ready for it to come back now, and when the time comes you’ll be making out like Rob Lowe in St Elmo’s Fire.
4x BOXES KWALITY SALTED ANCHOVIES
Current bid $10, Closes Monday
This Filipino supermarket appears to have gone under and, honestly, it’s worth clicking through the pages of stuff. Keep an eye on the best before dates, especially on the HUNDREDS OF BEERS that went off in 2022 – but there’s some real bargains to be had. For instance, this lot of eight dozen jars of anchovies, expiring 2027.
2x BOXES ANTIFLATULENT
Current bid $10, Closes Monday
Also from the above supermarket. I did not even know this was a thing, but now can be an amazing gift I can send anyone who befouls the air around me (you know who you are). 48 bottles, expires 2030.
55 MINIATURE TROPHIES
Current bid $40, Closes today
Surely some of you are wondering what to give the winners of this year’s company Christmas party lawn bowls event and your wondering ends here.
The To-Do List.
By Simon
FRIDAY 14TH
ARTISAN CHOCOLATES
Treadler, Free
New show with Dr P and Shiraz Sadikeen at Treadler, with Te Maari. There’s an artist talk with Dr P on Saturday, with tea and toast at midday.
MULTIPHONICS
Audio Foundation, $20
Extremely nerdy experimental speaker/art noise event — read the blurb on the other end of the link if you want to disassociate for a few minutes (warning: long, niche).
DICK MOVE
Double Whammy, $15
First show of the album release tour for Dream Believe Achieve. It should be a fairly hectic, enjoyable time and Dick Move are the long overdue winners of our Cringe Band Name of the Week Award.
DANE MITCHELL AT TWO ROOMS.
SATURDAY 15TH
DANE MITCHELL, ARCHIVE OF DUST, ROOM 18
Two Rooms, Free
The new instalment of Mitchell’s Archive of Dust features these amazing looking photos of bacterial cultures of dust samples taken from various art environments over the past 24 years. This edition features the dust of the room where the British Museum keeps The Parthenon Marbles and some associated bits and pieces.
LENNY KRAVITZ
Spark Arena, From $99
There’s no way this isn’t going to be full of people just waiting for a repeat of his 2015 wardrobe malfunction. Support from Troy Kingi, whose wardrobe seems pretty malfunction-proof to me.
MEET THE MAKERS MARKET
Airedale St, Free
Tick some holiday shopping off – lots of cool makers here, including Walk in the Park, Jino Ceramic Studios, and friend of the newsletter Simon (another Simon) is selling his wares too (Antifa Tchotchkes).
SUNDAY 16TH
SUBMISSION PARTY
Open, Free
Want to submit on the Unitary Plan Change 120 but can’t face the thought of doing it alone and sober? This is for you.

THE FADEAWAYS AT WHAMMY.
MONDAY 17TH
THE FADEAWAYS
Whammy, $26
Excitable Japanese garage punks. A recipe with a 100% success rate.
TUESDAY 18TH
DOJA CAT
Spark Arena, From $199
First date worldwide for the Vie album tour which is going to run for just over a year, so there could be some quite good nervous energy expelling on stage. Support from Sailorr.
WEDNESDAY 19TH
METALLICA
Eden Park, From $150
Surely Helen Clark must rue the day she dared to publicly worry about having a little peace and quiet as every single time something potentially noisy is going to happen in Mt Eden she is collectively imagined as Grinch-like, lurking behind nearby bushes waiting to call noise control. This will be really noisy though. Support from Evanescence and Suicidal Tendencies.
THURSDAY 20TH
AN EVENING WITH PRISCILLA PRESLEY: LIFE AFTER ELVIS
Bruce Mason, From $99
Surely this is not the part of her life that everyone wants to hear about. She was good in the original Naked Gun though so if she covers that it might be quite good.
